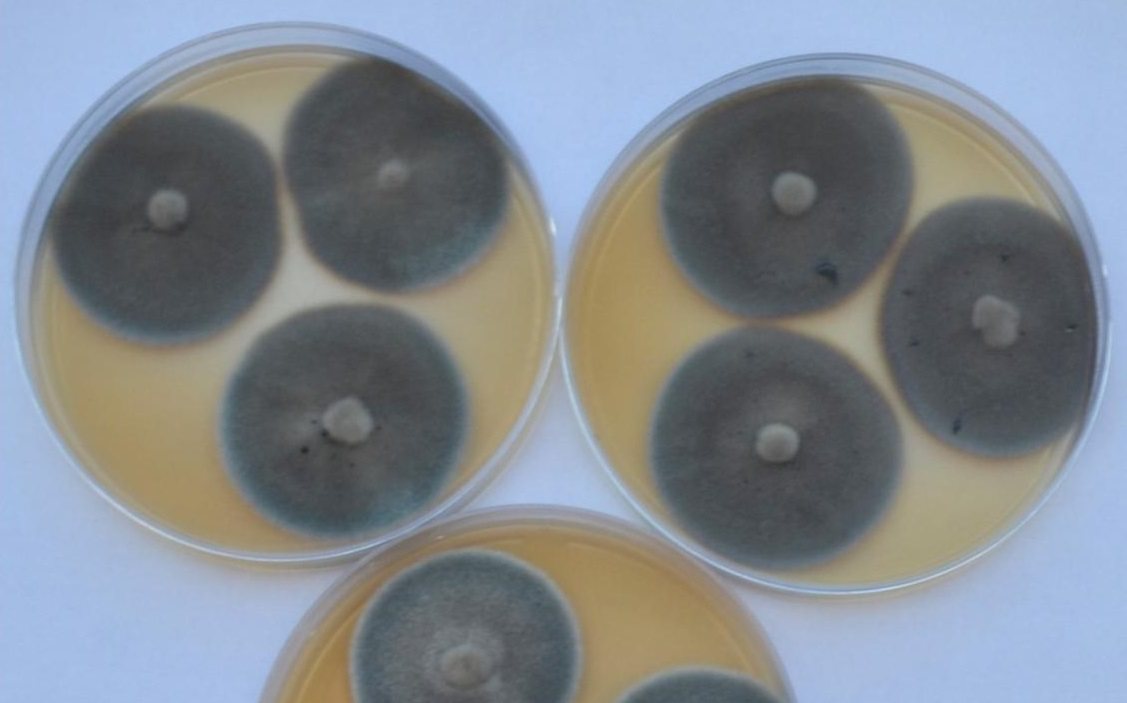
Pseudomonodictys pantanalensis sp. nov. A73 crescendo em meio de cultura - Foto por: Jaqueline Senabio/Pesquisadora

Noticias Ciência/Pesquisa
Pterossauros jovens tinham comportamento semelhante ao das aves atuais
Descoberta em 2014, fósseis da espécie foram encontrados no interior do Paraná, em rochas do município Cruzeiro do Oeste e representou um importante achado para a paleontologia nacional. Essa foi a primeira vez que esses répteis alados foram encontrados fora da Região Nordeste.

Pesquisas são desenvolvidas para melhorar produção de mandioca após diminuição da área de cultivo em MT
A Empaer disse que a queda da área aconteceu devido à falta de materiais de propagação produtivos e uma pesquisa desenvolvida pela empresa pretende realizar recomendações técnicas, para que os produtores que apostarem na cultura tenham mais garantias de ter bons resultados.
Pesquisa de MT investiga uso de bagaço e borra de vinícolas para tratamento e prevenção de doenças
Embora esses resíduos sejam descartados, há indícios de que eles possuam grandes quantidades de substâncias antioxidantes, entre outras, que são potencialmente benéficas para tratar e prevenir diversas doenças.
Pesquisadores de MT descobrem nova espécie de fungo capaz de descontaminar solos com mercúrio
O fungo recebeu o nome Pseudomonodictys pantanalensis, em homenagem ao bioma Pantanal. Conforme os pesquisadores, ele vive em associação com a planta pantaneira conhecida como Corticeira, ou pelo nome científico Aeschynomene fluminensis, encontrada na região de Poconé (a 105 km de Cuiabá).
Embrapa testa bioinsumo para aumentar produção de lúpulo no Brasil
A exemplo de outras culturas em que os produtores já utilizam bioinsumos (insumos biológicos) para potencializar a produtividade, experimentos com mudas inoculadas com a bactéria Azospirillum possibilitaram aumento de 52% de biomassa na parte aérea da planta.
Pesquisa apoiada pela Fapemat estuda uso de óleo de pequi e baru na nutrição de frangos
Uma pesquisa realizada com o apoio da Fundação de Amparo à Pesquisa do Estado de Mato Grosso (Fapemat) busca melhorar a qualidade animal e segurança alimentar com a utilização de óleos extraídos do pequi e do baru na dieta de aves.
Pesquisa investiga mortalidade por covid-19 em 31 hospitais de todo o Brasil
Estiveram envolvidos com o trabalho 87 pesquisadores, de 37 instituições de ensino e pesquisa em saúde, que analisaram 6.556 internações para covid-19 durante o período do estudo.
Queimadas florestais influenciaram no aumento de casos de Covid-19, diz pesquisa
Esse fato foi comprovado pelo estudo Covid-19 e Queimadas na Amazônia Legal e no Pantanal aspectos cumulativos e vulnerabilidades, da Fundação Oswaldo Cruz (Fiocruz), publicado no livro Covid-19 no Brasil, que mostra um aumento nos casos de coronavírus em regiões onde ocorreram incêndios florestais, como nas áreas da Amazônia Legal e do Pantanal.
Vacina personalizada contra o câncer tem resultados esperançosos na Inglaterra
A vacina foi aplicada como tratamento complementar em cânceres de cabeça e pescoço, aqueles que acometem as regiões da boca, faringe (garganta), laringe e cavidade nasal, bem como a pele, glândulas salivares, vasos sanguíneos, músculos e nervos da região, além da glândula tireoide.
Comentários de ódio na internet afetam psicologicamente
Viver conectado é quase uma necessidade nos dias atuais. Quase não há mais separação do mundo virtual para o real. Estamos conectados 24 horas por dia.








